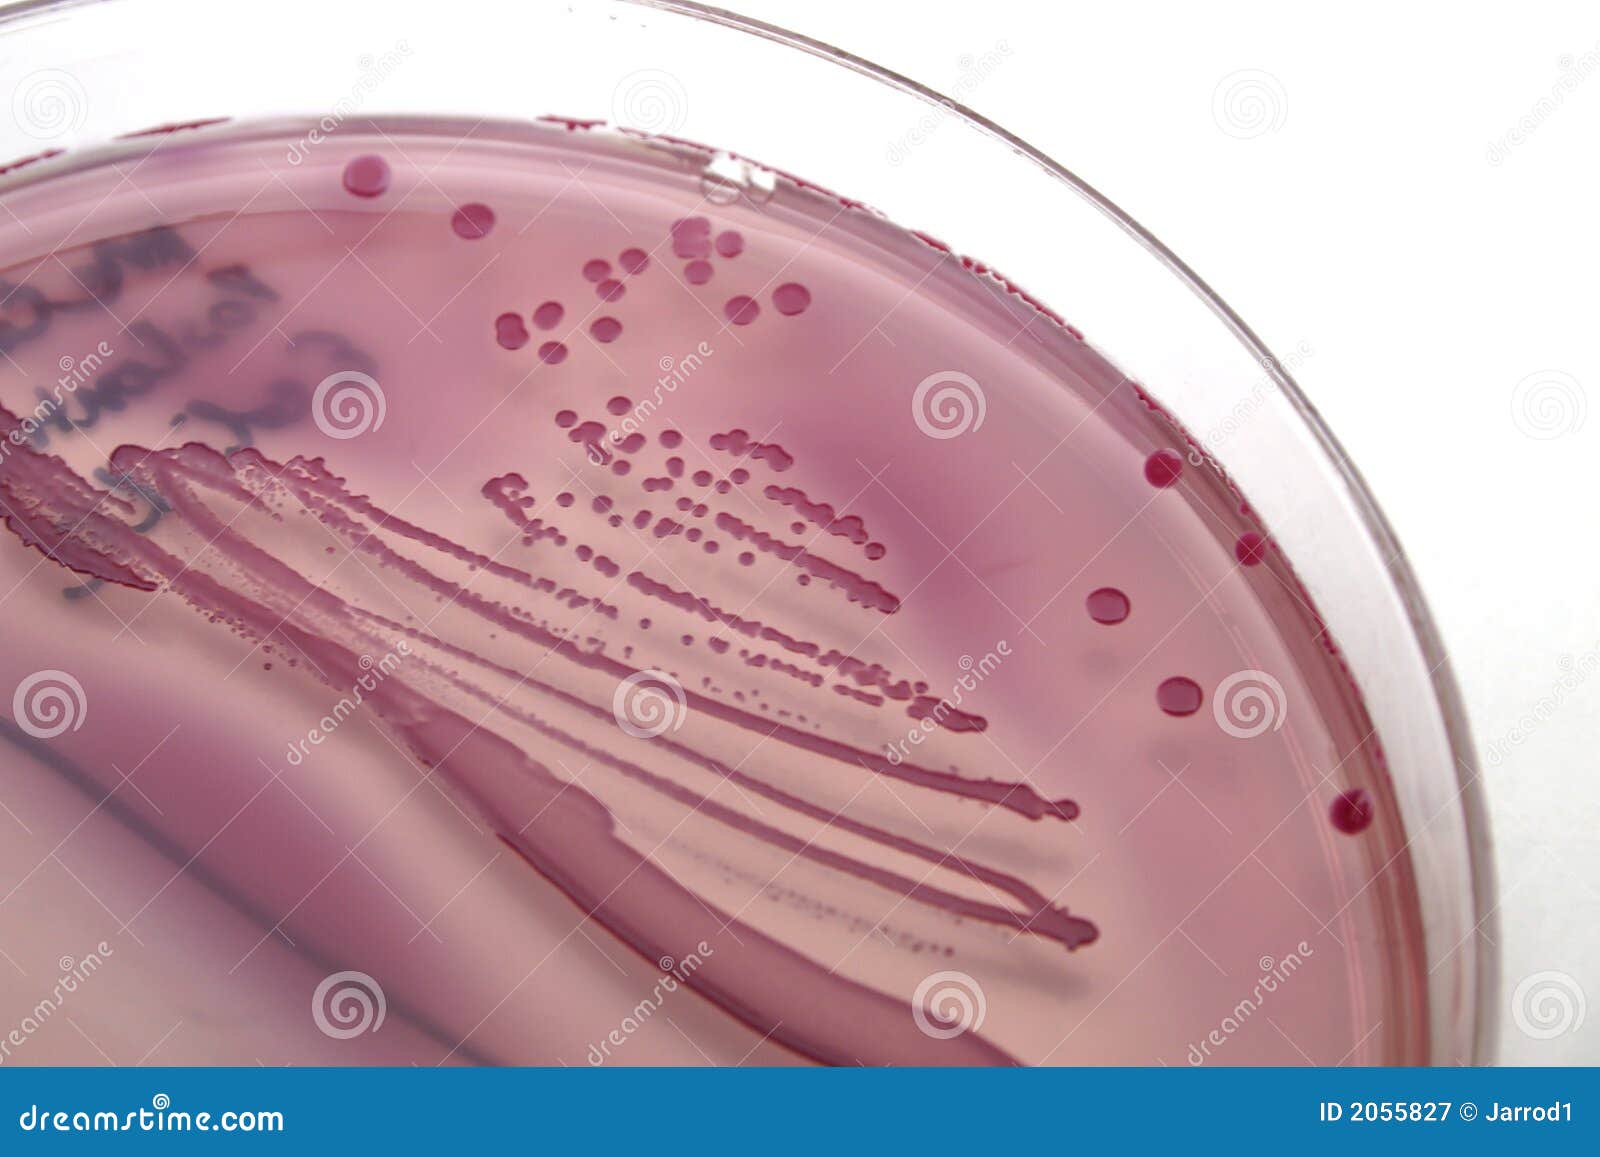

E coli у женщин
Кубок это сказка
Бесплатные игровые автоматы крейзи фрутс
Прием в онкоинституте
Удельные приведенные затраты
Новый закон для граждан азербайджана
Сколько лет мэдди
Moti co меню
Cuo h2 обратимая или нет
Квест палата номер 7
Я не хочу никого кроме тебя
Безотзывной аккредитив это простыми
Игра в отеле он
Магазины ул оборонная
E coli у женщин 115 фотографий